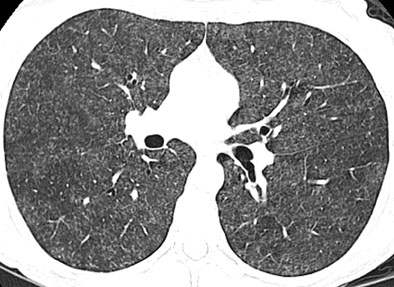

https://t.me/click_here_here/9
Moms Boobs Com
Girls Play With There Tits
Lesbian Breast Massages
Xxx Bonnie And Clyde Porno Cum
Erotic nude thin woman
Pelicula porno violacion
Public Boner Tumblr
Hentai Milk
Horny pornstar in Exotic Big Ass, Interracial porn clip
30 second handjob
Harder fuck me harder daddy
Hot naked nanny
Truth or dare
Hot Retarded Girl 112 photos